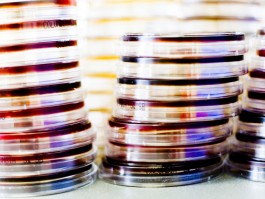

Process & Analytical Development
Process development is the link between research and the subsequent commercial production of biopharmaceuticals. Its goal is to develop a cost-effective and robust manufacturing process that can be validated and yields maximum quantities of high-quality product, while complying with all process and product specifications.

With over 30 years of experience and more than 200 successfully accomplished projects for our customers across the globe, Wacker Biotech has the expertise to develop processes that satisfy customers’ demands for rapid availability of clinical materials, while bearing in mind the long-term demands of commercial production processes. We serve customers under the regulatory jurisdiction of the European Medicines Agency (EMA), the U.S. Food and Drug Administration (FDA) and similar agencies of other regions including South Korea and Japan.
The BioProcess Development department with more than 80 full-time employees (the vast majority with academic degrees) is focused solely on process development, material supply for preclinical trials, strain/analytical development, process transfer and process characterization.
Product/Customer Spotlights
Development of a cancer drug from strain to approval
Based on a production strain of Escherichia coli, the new WACKER process for Spectrila® utilizes proprietary technologies such as high-cell-density fermentation. The WACKER contribution to the Spectrila® drug substance approval covers biopharmaceutical process development in its entirety – from generating the cell line, to establishing and validating the analytical methods for process control and release of the bulk drug, to the final, validated, industrial-scale production process. Wacker Biotech now provides medac with the drug substance from its modern GMP facility in Jena for market supply of Spectrila®. It obtained approval from the European Medicines Agency (EMA) in 2016 and from the FDA in 2018.
Development of a novel regenerative therapeutic for phase I/II
CTR-107 is the first program to obtain U.S. FDA Rare Pediatric Disease Designation for treatment of Familial Exudative Vitreoretinopathy (FEVR).
“As a potential break-through program for a rare, devastating retinal disease with no therapeutic options for patients, we selected Wacker Biotech as our CDMO partner for CTR-107 development because of their long-standing experience and deep understanding of protein chemistry, and shared urgency in advancing transformative science.”
Development of a mRNA-based therapeutic
“We have established a very good collaborative R&D footing with WACKER and value its broad expertise in the production of mRNA active ingredients – expertise that we were able to use to turn our innovative technology into a product. WACKER plays a special role in the market, as it combines many years of experience in the toll manufacturing of complex biopharmaceuticals with the capabilities of its own Corporate R&D unit. We are delighted to now see our innovative mRNA active ingredient move from the laboratory to regulated production. This marks an important milestone for our company and opens a new chapter in our joint collaboration.”
Better with WACKER
We look forward to bringing your biologics to life.